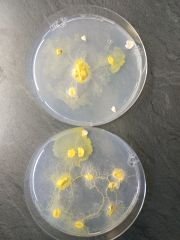
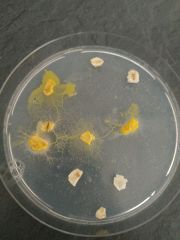
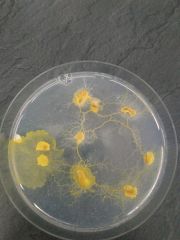
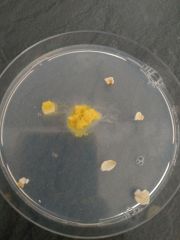

This special page shows all uploaded files.
| Date | Name | Thumbnail | Size | Description | Versions |
|---|---|---|---|---|---|
| 16:46, 11 January 2021 | 0fba5a3a-c8fa-44fc-a0c3-f8d548f2eccb.mp4 (file) | 1.98 MB | File uploaded with MsUpload | 2 | |
| 14:32, 11 January 2021 | Dataset-3-microscopy-dn - Progress Video.mp4 (file) | 1.5 MB | File uploaded with MsUpload | 1 | |
| 14:32, 11 January 2021 | Dataset2-microscopy-2ndattempt - Progress Video.mp4 (file) | 2.47 MB | File uploaded with MsUpload | 1 | |
| 13:33, 21 December 2020 | Slime3-1.jpg (file) |  |
4.3 MB | File uploaded with MsUpload | 1 |
| 13:32, 21 December 2020 | Slime2-dn.jpg (file) |  |
4.34 MB | File uploaded with MsUpload | 1 |
| 13:32, 21 December 2020 | Slime2-4dn.jpg (file) |  |
4.55 MB | File uploaded with MsUpload | 1 |
| 13:32, 21 December 2020 | Slime2-3dn.jpg (file) |  |
4.67 MB | File uploaded with MsUpload | 1 |
| 13:32, 21 December 2020 | Slime2-2dn.jpg (file) |  |
4.51 MB | File uploaded with MsUpload | 1 |
| 13:30, 21 December 2020 | Slime1-dn.jpg (file) |  |
4.18 MB | File uploaded with MsUpload | 1 |
| 13:30, 21 December 2020 | Slime1-3dn.jpg (file) |  |
4.25 MB | File uploaded with MsUpload | 1 |
| 13:30, 21 December 2020 | Slime1-2dn.jpg (file) |  |
4.5 MB | File uploaded with MsUpload | 1 |
| 16:24, 13 December 2020 | Slime-together-dn.jpg (file) | |
3.5 MB | File uploaded with MsUpload | 1 |
| 16:23, 13 December 2020 | Slime2-3.jpg (file) |  |
3.53 MB | File uploaded with MsUpload | 1 |
| 16:23, 13 December 2020 | Slime2-4.jpg (file) |  |
4.23 MB | File uploaded with MsUpload | 1 |
| 16:23, 13 December 2020 | Slime2-2.jpg (file) |  |
3.51 MB | File uploaded with MsUpload | 1 |
| 16:23, 13 December 2020 | Slime2-5.jpg (file) |  |
4.19 MB | File uploaded with MsUpload | 1 |
| 16:22, 13 December 2020 | Slime1-3.jpg (file) |  |
4.23 MB | File uploaded with MsUpload | 1 |
| 16:22, 13 December 2020 | Slime1-5.jpg (file) |  |
4.19 MB | File uploaded with MsUpload | 1 |
| 16:22, 13 December 2020 | Slime1-1.jpg (file) |  |
5.07 MB | File uploaded with MsUpload | 1 |
| 16:22, 13 December 2020 | Slime1-4.jpg (file) | |
3.93 MB | File uploaded with MsUpload | 1 |
| 16:22, 13 December 2020 | Slime1-6.jpg (file) | |
4.23 MB | File uploaded with MsUpload | 1 |
| 16:21, 13 December 2020 | Muddy7.jpg (file) |  |
3.51 MB | File uploaded with MsUpload | 1 |
| 16:21, 13 December 2020 | Muddy6.jpg (file) |  |
2.65 MB | File uploaded with MsUpload | 1 |
| 16:21, 13 December 2020 | Muddy5.jpg (file) |  |
2.84 MB | File uploaded with MsUpload | 1 |
| 16:21, 13 December 2020 | Muddy4.jpg (file) |  |
2.99 MB | File uploaded with MsUpload | 1 |
| 16:21, 13 December 2020 | Muddy3.jpg (file) |  |
3.16 MB | File uploaded with MsUpload | 1 |
| 16:21, 13 December 2020 | Muddy2.jpg (file) |  |
2.69 MB | File uploaded with MsUpload | 1 |
| 16:21, 13 December 2020 | Muddy1.jpg (file) |  |
3.35 MB | File uploaded with MsUpload | 1 |
| 16:20, 13 December 2020 | Wet-leaves9.jpg (file) |  |
3.17 MB | File uploaded with MsUpload | 1 |
| 16:20, 13 December 2020 | Wet-leaves8.jpg (file) |  |
2.52 MB | File uploaded with MsUpload | 1 |
| 16:20, 13 December 2020 | Wet-leaves7.jpg (file) |  |
3.18 MB | File uploaded with MsUpload | 1 |
| 16:20, 13 December 2020 | Wet-leaves6.jpg (file) |  |
2.8 MB | File uploaded with MsUpload | 1 |
| 16:20, 13 December 2020 | Wet-leaves5.jpg (file) |  |
2.9 MB | File uploaded with MsUpload | 1 |
| 16:20, 13 December 2020 | Wet-leaves4.jpg (file) |  |
4.08 MB | File uploaded with MsUpload | 1 |
| 16:20, 13 December 2020 | Wet-leaves3.jpg (file) |  |
3.03 MB | File uploaded with MsUpload | 1 |
| 16:20, 13 December 2020 | Wet-leaves2.jpg (file) |  |
3.65 MB | File uploaded with MsUpload | 1 |
| 16:20, 13 December 2020 | Wet-leaves1.jpg (file) |  |
4.06 MB | File uploaded with MsUpload | 1 |
| 16:05, 13 December 2020 | Slime2-day5.jpeg (file) |  |
4.19 MB | File uploaded with MsUpload | 1 |
| 16:05, 13 December 2020 | Slime2-day4-2.jpeg (file) |  |
4.23 MB | File uploaded with MsUpload | 1 |
| 16:05, 13 December 2020 | Slime2-day4-1.jpeg (file) | |
3.51 MB | File uploaded with MsUpload | 1 |
| 16:05, 13 December 2020 | Slime2-day3.jpeg (file) |  |
4.35 MB | File uploaded with MsUpload | 1 |
| 16:05, 13 December 2020 | Slime2-day2.jpeg (file) |  |
4.35 MB | File uploaded with MsUpload | 1 |
| 15:51, 13 December 2020 | Muddy-water7.jpeg (file) |  |
3.51 MB | File uploaded with MsUpload | 1 |
| 15:51, 13 December 2020 | Muddy-water6.jpeg (file) |  |
2.65 MB | File uploaded with MsUpload | 1 |
| 15:51, 13 December 2020 | Muddy-water5.jpeg (file) |  |
2.84 MB | File uploaded with MsUpload | 1 |
| 15:51, 13 December 2020 | Muddy-water4.jpeg (file) |  |
2.99 MB | File uploaded with MsUpload | 1 |
| 15:51, 13 December 2020 | Muddy-water3.jpeg (file) |  |
2.54 MB | File uploaded with MsUpload | 1 |
| 15:51, 13 December 2020 | Muddy-water2.jpeg (file) |  |
2.69 MB | File uploaded with MsUpload | 1 |
| 15:51, 13 December 2020 | Muddy-water1.jpeg (file) |  |
3.35 MB | File uploaded with MsUpload | 1 |
| 15:48, 13 December 2020 | Wet-leaves9.jpeg (file) |  |
2.52 MB | File uploaded with MsUpload | 1 |